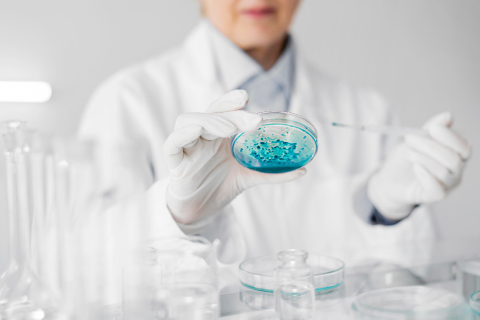
Od formulacji do claimu – jak decyzje technologiczne budują wiarygodność produktu?

Sensoryka kosmetyku kojarzy się tym, jak "zachowuje" się on w czasie aplikacji (między innymi z tym, jak się rozprowadza), a także z tym, czy jest lekki oraz jakie wrażenie pozostawia na skórze. O sensoryce produktu decyduje szereg działań na etapie tworzenia formulacji. Zależy ona więc od struktury układu, właściwości surowców i sposobu, w jaki formulacja reaguje na siły podczas aplikacji.
Sensoryka kosmetyku to o wiele więcej, niż nice feel
Sensoryka produktów kosmetycznych jest opisywana najczęściej przez pryzmat odczuć użytkowych, takich jak lekkość, kremowość czy „bogate” wykończenie, jednak są to jedynie końcowe efekty złożonych procesów fizycznych zachodzących na poziomie struktury całego układu. Jak pokazuje literatura naukowa, odczucia aplikacyjne stanowią bezpośrednią konsekwencję decyzji materiałowych i strukturalnych podejmowanych już na etapie projektowania emulsji [1].
Współczesne podejście do sensoryki coraz częściej opiera się na jej powiązaniu z mierzalnymi parametrami fizycznymi, takimi jak właściwości reologiczne i mikrostruktura formulacji, co umożliwia przewidywanie profilu sensorycznego produktu jeszcze przed etapem jego finalnej oceny [1], [2]. Sensoryka przestaje być w tym ujęciu elementem „dopieszczanym” na końcu procesu rozwoju, a staje się cechą projektowaną poprzez świadomy dobór składników i kontrolę parametrów strukturalnych.
Sensoryka jako zjawisko mierzalne i systemowe
W literaturze naukowej sensoryka produktów kosmetycznych coraz częściej opisywana jest jako zjawisko o charakterze systemowym. Wynika ono z właściwości materiałowych składników oraz z tego, jak formulacja zachowuje się pod wpływem sił mechanicznych podczas aplikacji. Badania nad oceną sensoryczną pokazują, że takie cechy jak kremowość, łatwość rozprowadzania czy body produktu są powtarzalne pomiędzy różnymi panelami oceniającymi i mogą być korelowane z konkretnymi parametrami fizycznymi formulacji. [1]
Równolegle badania reologiczne emulsji pokazują, że takie parametry, jak lepkość przy niskim ścinaniu, yield stress czy charakter shear-thinning stanowią pomost łączący strukturę emulsji z jej odbiorem sensorycznym [2].

Reologia jako pomost między strukturą emulsji a percepcją użytkownika
Najważniejszym elementem łączącym strukturę formulacji z jej percepcją sensoryczną są właściwości reologiczne. Parametry takie jak:
lepkość przy niskich prędkościach ścinania,
yield stress,
charakter shear-thinning
opisują, w jaki sposób emulsja reaguje na siły działające podczas nabierania produktu, jego rozprowadzania i masażu na skórze. Badania nad emulsjami kosmetycznymi pokazują, że to właśnie te cechy najsilniej korelują z deskryptorami sensorycznymi, jak kremowość, body, kontrola aplikacji czy postrzegane bogactwo tekstury. [2-4]
Badania wskazują również, że yield stress pozostaje w ścisłym związku z postrzeganą pourability i spreadability produktu. Z kolei lepkość mierzona przy niskim ścinaniu wpływa na ocenę grubości, kremowości oraz ogólnego body emulsji. Charakter shear-thinning odpowiada natomiast za poczucie kontroli podczas rozprowadzania – pozwala zachować stabilną strukturę produktu w spoczynku, a jednocześnie ułatwia jego rozpływ pod wpływem sił aplikacyjnych. [2], [4]
W praktyce oznacza to więc, że sensoryka kosmetyku jest określona o wiele wcześniej, niż podczas kontaktu produktu ze skórą, bo na poziomie mikrostruktury emulsji..
Funkcjonalne role składników w budowie sensoryki emulsji
W projektowaniu sensoryki kluczowe jest nie tyle to, jakie konkretnie składniki znajdują się w formulacji, ile jaką funkcję pełnią one w mikrostrukturze emulsji.
Składniki strukturotwórcze – takie jak alkohole tłuszczowe, długołańcuchowe estry czy komponenty o charakterze krystalicznym – odpowiadają za budowę i wzmocnienie sieci strukturalnej emulsji. Ich obecność zwiększa lepkość przy niskim ścinaniu oraz wartość yield stress, co sensorycznie przekłada się na odczucie kremowości, body i stabilności tekstury. [2], [3]
Jednocześnie pozwalają one zachować spójną strukturę produktu w spoczynku, przy zachowaniu zdolności do kontrolowanego rozpadu pod wpływem sił działających podczas aplikacji.
Składniki modulujące mobilność struktury – takie jak bardziej mobilne estry czy emolienty o niższej lepkości kinematycznej – wpływają na to, jak emulsja reaguje na rosnące ścinanie. Działają one jak plastyfikatory sieci strukturalnej: zmniejszają opór podczas rozprowadzania i poprawiają poślizg, bez potrzeby zasadniczej zmiany architektury całej formulacji. [4], [5]
Komponenty filmotwórcze kształtują zachowanie produktu po aplikacji, wpływając na ciągłość filmu na skórze, odczuwaną gładkość i after-feel. [6]
Emulgator jako decyzja sensoryczna, nie tylko stabilizująca
Jednym z najczęściej przywoływanych badań pokazujących zależność między strukturą emulsji a jej odbiorem sensorycznym jest praca Morávkovej i Filipa, poświęcona wpływowi rodzaju emulgatora na właściwości reologiczne i sensoryczne lotionów kosmetycznych. [3]
Autorzy przygotowali serię emulsji O/W, które różniły się wyłącznie zastosowanym systemem emulgującym. Dzięki temu możliwe było jednoznaczne powiązanie obserwowanych różnic w zachowaniu i sensoryce produktu właśnie z tym czynnikiem.
Wyniki badań pokazały, że sama zmiana emulgatora prowadzi do istotnych różnic w parametrach takich jak lepkość w niskim zakresie ścinania oraz wartość yield stress. Co istotne, parametry te bezpośrednio przekładały się na ocenę sensoryczną: emulsje o wyższym yield stress były postrzegane jako bardziej kremowe i „bogatsze”, natomiast te o niższym oporze początkowym – jako lżejsze i łatwiejsze w aplikacji. [3]
Badanie to potwierdza, że emulgator nie pełni jedynie roli stabilizującej, ale aktywnie współtworzy strukturę układu i jego profil sensoryczny. W praktyce oznacza to, że różne klasy emulgatorów – w tym systemy oparte na surowcach poliglicerynowych – mogą prowadzić do odmiennych profili sensorycznych, nawet jeśli zapewniają porównywalny poziom stabilności formulacji. [3], [4]
Emolienty jako nośniki sensoryki
Ważnym uzupełnieniem badań nad reologią są prace poświęcone sensorycznej charakterystyce emolientów. Parente, Gámbaro i Ares wykazali, że różne klasy emolientów generują powtarzalnie odmienne profile sensoryczne, obejmujące łatwość rozprowadzania, lepkość resztkową, połysk oraz odczucie oiliness, a różnice te wynikają z właściwości fizykochemicznych samych emolientów, a nie z ich zastosowania w konkretnej recepturze. [5], [6]
Oznacza to, że już na etapie doboru emolientu – niezależnie od tego, czy będzie to ester o niskiej lepkości i wysokim poślizgu, neutralny trigliceryd średniołańcuchowy czy bardziej „ciężki” ester długołańcuchowy – możliwe jest świadome kształtowanie profilu sensorycznego produktu.
Wyniki badań pokazują, że emolienty pełnią różne funkcje sensoryczne w zależności od etapu aplikacji. Podczas pierwszego kontaktu ze skórą kluczowe znaczenie mają emolienty o niskiej lepkości kinematycznej – to one zmniejszają opór początkowy i kształtują pierwsze wrażenie lekkości.W trakcie rozprowadzania coraz większą rolę odgrywają emolienty o charakterze strukturalnym, które – poprzez wpływ na yield stress i shear-thinning – budują poczucie kontroli, kremowości i spójności tekstury. Po aplikacji natomiast właściwości filmotwórcze oraz mobilność pozostałego filmu olejowego wpływają na after-feel, postrzeganą gładkość i długotrwały komfort użytkowania. [5]
Uzupełnieniem badań panelowych są prace analizujące wpływ emolientów w rzeczywistych formulacjach. Lukic i współautorzy pokazali, że w przypadku kremów W/O zmiana emolientu (przy zachowaniu tej samej architektury formulacyjnej) prowadzi do istotnych różnic w teksturze, odczuciach sensorycznych oraz mierzalnych parametrach skóry in vivo. [7] Potwierdza to rolę emolientów jako kluczowego ł ącznika pomiędzy strukturą formulacji a zachowaniem produktu na skórze.

Spreadability jako funkcja mechaniki aplikacji
Mechanika rozprowadzania produktu jest jednym z kluczowych elementów sensoryki. Savary, Grisel i Picard pokazali, że spreadability może być oceniana zarówno metodami instrumentalnymi, jak i sensorycznymi – a oba podejścia prowadzą do spójnych wniosków. [8]
Badania te wskazują, że różne emolienty wpływają na sposób, w jaki produkt rozkłada się na skórze pod wpływem sił ścinających, co bezpośrednio przekłada się na postrzeganą kremowość i kontrolę aplikacji. W praktyce oznacza to, że odpowiedni dobór emolientów o zróżnicowanej lepkości kinematycznej i polarności umożliwia kontrolę play time produktu bez konieczności modyfikowania architektury całej formulacji.
Tarcie powierzchniowe i rola dodatków proszkowych
Coraz większą uwagę poświęca się także roli tarcia powierzchniowego w odbiorze tzw. skin feel. Badania Timm i współautorów pokazały, że dodatki proszkowe mogą w istotny sposób zmieniać współczynnik tarcia pomiędzy skórą a aplikowanym produktem, co bezpośrednio przekłada się na odczucia takie jak gładkość, jedwabistość czy suchy finisz [9].
Podobne wnioski płyną z analiz sensorycznych proszków kosmetycznych, które wskazują, że nawet niewielkie ilości dodatków mineralnych lub organicznych mogą wyraźnie modyfikować after-feel produktu. [10]
Z perspektywy surowcowej komponenty proszkowe stanowią skuteczne narzędzie do fine-tuningu sensoryki, szczególnie w końcowej fazie aplikacji.

Sensoryka poza INCI – wspólny wniosek badań
Sensoryka produktu kosmetycznego nie wynika bezpośrednio z listy składników INCI, lecz z funkcji materiałowych, jakie składniki te pełnią w strukturze formulacji.
Rolą dystrybutora surowców nie jest projektowanie formulacji ani rekomendowanie gotowych receptur, lecz zapewnienie dostępu do składników o jasno określonych funkcjach sensorycznych oraz do wiedzy, która pozwala właściwie interpretować ich działanie w świetle dostępnych danych.
Takie podejście umożliwia zespołom R&D traktowanie sensoryki jako cechy projektowanej w sposób świadomy i oparty na danych, a nie jedynie ocenianej retrospektywnie na końcu procesu rozwoju produktu.
Bibliografia
[1] Masnou I., Poncet S., Sensory Evaluation in Cosmetic Product Development, International Journal of Cosmetic Science.
[2] Morávková T., Rheological and Textural Properties of Cosmetic Emulsions, Applied Rheology.
[3] Morávková T., Filip P., The Influence of Emulsifier on Rheological and Sensory Properties of Cosmetic Lotions.
[4] Concentration-Dependent Rheological and Sensory Correlations in Cosmetic Emulsions, MDPI.
[5] Parente G., Gámbaro A., Ares G., Sensory Characterization of Emollients, Journal of Sensory Studies.
[6] Parente M.E., Gámbaro A., Solana G., Study of sensory properties of emollients used in cosmetics and their correlation with physicochemical properties, Journal of Cosmetic Science, 56, 175–182 (2005).
[7] Lukic M. et al., Influence of emollient on textural, sensorial and in vivo skin performance, International Journal of Cosmetic Science, 34, 140–149 (2012).
[8] Savary G., Grisel M., Picard C., Impact of emollients on the spreadability properties of cosmetic products, Colloids and Surfaces B, 102, 371–378 (2013).
[9] Timm K. et al., Investigation of friction and perceived skin feel after application of cosmetic powders, International Journal of Cosmetic Science, 34, 458–465 (2012).
[10] Moussour M. et al., Sensory Analysis of Cosmetic Powders, International Journal of Cosmetic Science.